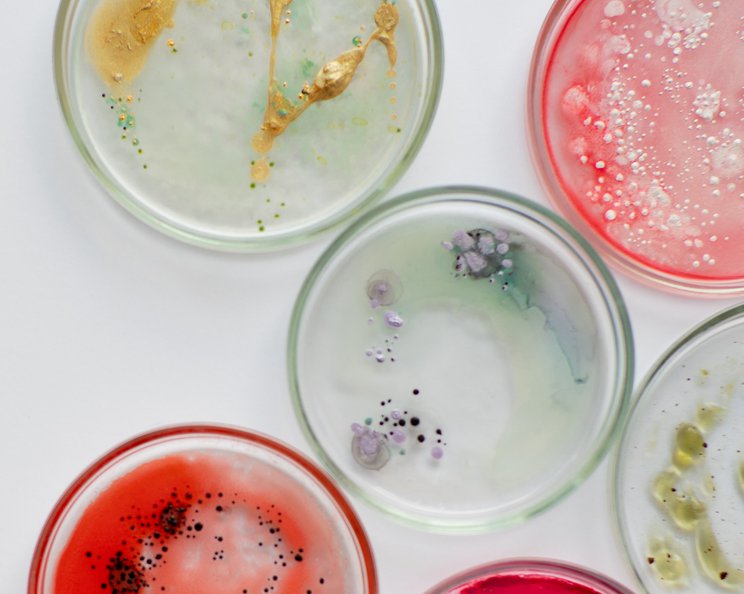
Extended-spectrum Beta-Laktamase (ESBL)

Extended-spectrum Beta-Laktamase (ESBL)
Beta-Laktamasen (auch β-Laktamasen) sind von Bakterien produzierte (exprimierte) Enzyme, die Beta-Laktam-Antibiotika spalten können.
ESBL ist ein Resistenzmechanismus von Bakterien gegen Beta-Laktam-Antibiotika. Alle Beta-Laktam-Antibiotika enthalten einen Beta-Laktam-Ring als essenziellen Bestandteil für die Bakterien-abtötende Wirkungsweise. Dazu gehören Antibiotika aus den Gruppen der Penicilline, Cephalosporine, Carbapeneme und Monobactame. Der Beta-Laktam-Ring bindet irreversibel an wichtige Enzyme für den Zellwandaufbau und hemmt so die Zellwand-Synthese. Dieser Mechanismus wirkt nur auf Bakterien abtötend (bakterizid), die sich in der Zellteilung befinden. Ruhende Erreger, die sich gerade nicht teilen, werden lediglich an der Vermehrung gehindert (bakteriostatische Wirkung).
Beta-Laktamasen und Extended-spectrum Beta-Laktamasen
Beta-Laktamasen spalten meist spezifisch entweder Penicilline, Cephalosporine, Carbapeneme oder Monobactame.
Extended-spectrum Beta-Laktamasen (auch Breitspektrum Beta-Laktamase; ESBL) hingegen spalten ein erweitertes Spektrum an Beta-Laktam-Antibiotika. ESBL exprimierende Bakterien sind resistent sowohl gegen Penicilline als auch Cephalosporine und einige Monobactame. Durch die Öffnung (Hydrolysierung) des Beta-Laktam-Rings verlieren die Antibiotika ihre bakterizide sowie bakteriostatische Wirkung. Darüber hinaus können die Spaltprodukte an Proteine des menschlichen Körpers binden und dadurch allergische Reaktionen auslösen.
Welche Bakterien produzieren ESBL?
ESBL werden von unterschiedlichen gram-negativen Bakterien aus der Ordnung der Enterobakterien produziert.
Enterobakterien sind ein Teil der natürlichen Darmflora des Menschen. Außerhalb des Darms können sie insbesondere bei immungeschwächten Personen schwere Infektionen auslösen. Zu den relevantesten ESBL-exprimierenden Enterobakterien gehören Escherichia coli, Klebsiella pneumoniae sowie Salmonella spp.
Die Gene für ESBL sind auf ringförmigen DNA-Strängen, sogenannten Plasmiden lokalisiert. Diese Plasmide können direkt durch horizontalen Gentransfer von einem Bakterium auf ein anderes Bakterium übertragen werden. Das bedeutet, dass die ESBL-DNA nicht nur bei der Zellteilung als Erbgut auf Tochterzellen weitergegeben wird (vertikaler Gentransfer). Dadurch entstehen Resistenzen der Bakterien gegenüber Antibiotika.
Wie kann man sich schützen und was bedeutet das für Wunden?
ESBL-produzierende Bakterien werden durch Schmierinfektionen übertragen.
Dazu gehört auch die Übertagung über kontaminierte Flächen. Flächen und Gegenstände müssen daher konsequent und regelmäßig desinfiziert werden. Besonders über die Hände werden ESBL-exprimierende Bakterien von Trägern auf gefährdete Personen übertragen. In der Krankenhausumgebung, aber auch bei ambulanten Behandlungen sollte daher eine gute Handhygiene mit entsprechenden Desinfektionsmaßnahmen durchgeführt werden. Kittel sowie Handschuhe sind regelmäßig zu wechseln und entsprechend zu waschen bzw. zu entsorgen.
Die Infektionsgefahr für gesunde Menschen mit intaktem Immunsystem wird als sehr gering angesehen. In Krankenhäusern, ambulanten Praxen oder Pflegeheimen besteht die größte Ansteckungsgefahr. Insbesondere schlecht heilende, offene Wunden oder Öffnungen der Haut für Stomata oder Verweilkanülen werden von ESBL-produzierenden Bakterien besiedelt.
Die Therapie ESBL-produzierender Bakterien findet mit geeigneten Antibiotika statt, aber gestaltet sich häufig schwierig. Problematisch bei der Behandlung ist, dass ESBL-exprimierende Bakterien oft über weitere Resistenzmechanismen gegenüber anderen Antibiotika-Klassen verfügen. Dazu zählen unter anderem Fluorchinolone, Aminoglykoside oder Sulfonamide. Deshalb werden in erster Linie Carbapeneme, Monobactame, Glycylcycline oder Polymyxine für die Therapie eingesetzt. Allerdings werden zunehmend mehr gram-negative Bakterienstämme isoliert, die auch in der Lage sind, Carbapeneme zu spalten.




























